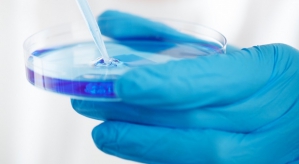

TECH | Amolyt Pharma passe dans le giron d'un groupe mondial
Le deal de la semaine - La biotech lyonnaise en phase III sur son premier candidat médicament dans les maladies endocriniennes et métaboliques rares qui avait bouclé une série C record début 2023 est rachetée par...